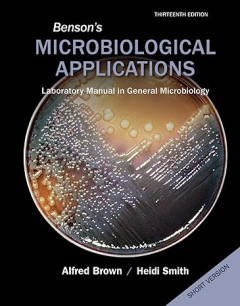

Ditapis dengan

The Golden Road: Sejarah yang terlupakan bagaimana peradaban India kuno menye…
Dalam buku ini, William Darlymple menyoroti posisi India yang sering terlupakan sebagai jantung Eurasia Kuno. Untuk pertama kalinya, ia memberi nama pada penyebaran ide-ide India yang mengubah dunia ini. Dari kuil Hindu terbesar di dunia di Angkor Wat hingga Buddhisme Tiongkok, dari perdagangan yang membantu mendanai Kekaisaran Romawi hingga penciptaan angka yang kita gunakan hingga saat ini (t…
- Edisi
- -
- ISBN/ISSN
- 9786232202160
- Deskripsi Fisik
- 544 hlm; 15 x 23 cm
- Judul Seri
- -
- No. Panggil
- 954 DAL t
English Classics : The War of the Worlds
No one would have believed in the last years of the nineteenth century that this world was bring watched keenly and closely by intelligences greater than man's and yet as mortal as his own; that as men busied themselves about their various concerns they were scrutinised and studied, perhaps almost as narrowly as a man with a microscope might scruitinise the transient creatures that swarm and mu…
- Edisi
- -
- ISBN/ISSN
- 9786020386621
- Deskripsi Fisik
- 312hlm; 11 x 18cm
- Judul Seri
- -
- No. Panggil
- 823 WEL e

E-book Thoughts and Ways of Thingking
"Why do we think differently from one another? Why do religious people adhere to their faith even against reason, whilst atheist thinkers label it “nonsense”? Why do some judges turn more to moral values and others less? Why do we attach different meanings to the same words? These questions can be tackled on psychological or sociological levels, but we can also analyze the subjects on the e…
- Edisi
- -
- ISBN/ISSN
- 9781911529231
- Deskripsi Fisik
- 186 hlmn
- Judul Seri
- -
- No. Panggil
- 121 BRO t

E-book Creativity in Education International Perspectives
Creativity has become a buzzword across all disciplines in education and across all phases, from early years through to tertiary education. Although the meaning of creativity can change vastly depending on the global educational setting, it is impossible to ignore the applicability and relevance of creativity as an educational tool, philosophical framework and pedagogical approach. Through case…
- Edisi
- -
- ISBN/ISSN
- 9781800080669
- Deskripsi Fisik
- 236 hlmn
- Judul Seri
- -
- No. Panggil
- 370.15 BRO c

Physical Science
Chapter 1 Nature Science Chapter 2 Motion Chapter 3 Forces and Newton's Laws Chapter 4 Work and Energy Chapter 5 Electricity Chapter 6 Thermal Energy Chapter 7 Magnetism and Its Use Chapter 8 Energy Sources and the Environment Chapter 9 Introduction to Waves Chapter 10 Sound Chapter 11 Electromagnetic Waves Chapter 12 Light
- Edisi
- -
- ISBN/ISSN
- 978007650870
- Deskripsi Fisik
- 852 hlm.; 22 cm x 29 cm
- Judul Seri
- -
- No. Panggil
- 530 MCL p
Ide-ide : Filsafat dan Agama Dulu dan Sekarang
Filsafat dan agama sudah setua sejarah tetapi tetap aktual seperti berita hari ini. Ide-ide dari sekian abad yang lalu masih membentuk cara hidup kita, cara pikir kita mengenai diri sendiri.
- Edisi
- -
- ISBN/ISSN
- 9796727455
- Deskripsi Fisik
- 263 hlm; 17 x 23cm
- Judul Seri
- -
- No. Panggil
- 210.1 SMI i
E-book Hong Kong : The Rise and Fall of One Country, Two Systems
Chinese leaders were determined to make the agreed deal work. They consulted widely. In the years leading up to 1997 I met with top leaders several times a year, both as a governor of the American Chamber of Commerce and—more often and more significantly—as chair of the Economic Committee of the Business and Professionals Federation, a group of top Hong Kong business leaders that had helped…
- Edisi
- -
- ISBN/ISSN
- -
- Deskripsi Fisik
- -
- Judul Seri
- -
- No. Panggil
- 320.1 OVE h
E-book Forged in Genocide
In April 2022, colleagues and I went to the desert coastal town of Lüderitz inSouthern Namibia for work. Our group of three having met up in BloemfonteinSouth Africa, had driven west in ourbakkie(pickup truck) to the Northern CapeProvince. From there we continued north across the Orange River, which, follow-ing good rains, was filled to the brim, to arrive in Namibia. One night in Lüderitz,af…
- Edisi
- -
- ISBN/ISSN
- 978311137491
- Deskripsi Fisik
- 345 hlm
- Judul Seri
- -
- No. Panggil
- 364.1516881 BLA f
E-book Dietary Guidelines for Americans 2020 - 2025
The foods and beverages that people consume have a profound impact on their health. The scientific connection between food and health has been well documented for many decades, with substantial and increasingly robust evidence showing that a healthy lifestyle—including following a healthy dietary pattern— can help people achieve and maintain good health and reduce the risk of chronic…
- Edisi
- -
- ISBN/ISSN
- -
- Deskripsi Fisik
- 164 hlm
- Judul Seri
- -
- No. Panggil
- 613.2 STO d

E-book Muhammad: A Very Short Introduction
As the founder of Islam, a religion with over one billion followers, Muhammad is beyond all doubt one of the most influential figures in world history. But learning about his life and understanding his importance has always proven difficult, as our only source of knowledge comes from the biography of him written by his followers, the reliability of which has been questioned by Western scholars.…
- Edisi
- -
- ISBN/ISSN
- 9780199559282
- Deskripsi Fisik
- 162 halaman.
- Judul Seri
- -
- No. Panggil
- 297.63 BRO m
E-book Meteorological Disasters in Medieval Britain (AD 1000?1500)
The impacts of natural hazards on human societies can be acute, far reaching and attimes surprising. As much as the products of hazards arising entirely by natural means,however, the disastrous circumstances created by such events are socially-createdphenomena. Not only are natural hazards themselves the product of a complex web ofEarth-system processes, their effect on human society is the res…
- Edisi
- -
- ISBN/ISSN
- 9783110719628
- Deskripsi Fisik
- -
- Judul Seri
- -
- No. Panggil
- 930.1 BRO m
E-book Space Business : Emerging Theory and Practice
The space age dawned in 1957 with the successful orbiting of Sputnik by the Soviet Union, and it surged forward with the Apollo moon land-ings, ushering in the era of satellites and deep space probes. This situation in which space business relied on space science probes, space shuttle flights, and satellite launches largely persisted until the…
- Edisi
- -
- ISBN/ISSN
- 9789819734306
- Deskripsi Fisik
- 330 hlm
- Judul Seri
- -
- No. Panggil
- 650.07 ALG s
E-book Egyptian Things : Translating Egypt to Early Imperial Rome
The Temple of Dendur stands grandly in New York’s Metropolitan Museum of Art (fig. 1). Reflecting pools and cool tan-marble floors stylishly evoke the Nile and its surroundings; an enormous semi-translucent ceiling remains a relic of 1970s mod-ernism; a vast wall of glass looks out to Central Park and E. Eighty-Fourth Street. All frame the Egyptian temple’s relocation to the former Sackler …
- Edisi
- -
- ISBN/ISSN
- 9780520402195
- Deskripsi Fisik
- 261 hlm
- Judul Seri
- -
- No. Panggil
- 732.8 KEL e
E-book The European Landing Obligation : Reducing Discards in Complex, Multi-…
In many countries, policies regarding reduction of unwanted catch anddiscards are crafted in response to concerns regarding accountability, conservation,and waste as well as scientific needs to fully account for all sources offishingmortality. It is important to note, however, that unwanted catch is minimal andmost, or all, of the catch has value in somefisheries. Utilisation rates are very hig…
- Edisi
- -
- ISBN/ISSN
- 9783030033088
- Deskripsi Fisik
- 438 hlm
- Judul Seri
- -
- No. Panggil
- 577.6 KAR t
E-book Dryland Social-Ecological Systems in Changing Environments
Drylands encompass land areas characterized by a mean annual precipitation to mean annual potential evapotranspiration ratio (known as the aridity index) below 0.65. The aridity index defines four distinct dryland subtypes: hyper-arid (aridity index < 0.05), arid (0.05 ?aridity index < 0.20), semi-arid (0.20 ?aridity index < 0.50) and dry sub-humid …
- Edisi
- -
- ISBN/ISSN
- 9789819993758
- Deskripsi Fisik
- 423 hlm
- Judul Seri
- -
- No. Panggil
- 910.02 SMI d
E-book A Samaritan State Revisited : Historical Perspectives on Canadian Fore…
Over the past two decades, Canadian international history has slipped its traditional North Atlantic moorings. Studies of Canada’s postwar relation-ships with a waning United Kingdom or an ascendant United States have faded in popularity, replaced with a stream of publications on relations with the decolonized states of Asia, Africa, and the Caribbean, countries whose citizens increasingly co…
- Edisi
- -
- ISBN/ISSN
- 9781773850405
- Deskripsi Fisik
- 393 hlm
- Judul Seri
- -
- No. Panggil
- 327.111 BLA a
E-book ‘Wit’s Wild Dancing Light’ : Reading the Poems of Alexander Pope
In her treatise on aesthetics, Feeling and Form, the twentieth-century philosopher Susanne K. Langer wrote that Wordsworth’s ‘Ode: Intimations of Immortality’ conveys above all the joyous experience of having such a great idea as that which informs the poem—the ‘excitement of it’ (Langer 1963, p. 219). Wordsworth’s ‘Ode’ …
- Edisi
- -
- ISBN/ISSN
- 9781800644137
- Deskripsi Fisik
- 314 hlm
- Judul Seri
- -
- No. Panggil
- 821 HUT w

E-book Present Over Perfect: Leaving Behind Frantic for a Simpler, More Soulf…
A few years ago, Shauna found herself exhausted and isolated, her soul and body sick. She was tired of being tired and burned out on busy. It seemed like almost everyone she talked to was in the same boat: longing for connection, meaning, and depth, but settling for busy. But then something changed. She decided to trade the hustle and bustle for grace, love, stillness, and play, and it chang…
- Edisi
- -
- ISBN/ISSN
- 9780310342991
- Deskripsi Fisik
- 243 halaman
- Judul Seri
- -
- No. Panggil
- 248 NIE p
E-book Migrant Ecologies : Environmental Histories of the Pacific World
The creation of—or even the existence of—a “Pacific World” is a question that has preoccupied scholars to a much greater degree than existential doubts have bothered historians of other oceanic basins. Economic historian Eric Jones and colleagues have written that “there can be no meaningful history ofthe whole Rim or Basin [ofthe Pacific] since there…
- Edisi
- -
- ISBN/ISSN
- 9780824892258
- Deskripsi Fisik
- 321 hlm
- Judul Seri
- -
- No. Panggil
- 990 BEA m
E-book What Works in Conservation 2021
This book is for people who have to make decisions about how best to support or conserve biodiversity. These include land managers, conservationists in the public or private sector, farmers, campaigners, advisors or consultants, policymakers, researchers or people taking action to protect local wildlife. What Works in Conservation and the associated synopses summari…
- Edisi
- -
- ISBN/ISSN
- 9781800642744
- Deskripsi Fisik
- 1041 hlm
- Judul Seri
- -
- No. Panggil
- 639.9 SMI w
E-book The Corporation as a Protagonist in Global History, c. 1550-1750
For almost two decades, historians and academics from a wide- range of sub- disciplinary backgrounds have been situating their research within a global context, crossing boundaries both geographically and methodologically, in such large numbers as to necessitate the emergence of a recognisably new field of enquiry: Global History. From comparative to connective histories, the …
- Edisi
- -
- ISBN/ISSN
- 9789004387850
- Deskripsi Fisik
- 343 hlm
- Judul Seri
- -
- No. Panggil
- 909.5 PET t

E-book Eyewitness Books: Food
Complements the new look of the Eyewitness series by exploring the myriad ways in which food affects our lives.
- Edisi
- -
- ISBN/ISSN
- 9780756611712
- Deskripsi Fisik
- 73 halaman, ilus.
- Judul Seri
- -
- No. Panggil
- 641.3 BRO e

E-book Benson's Microbiological Applications Short Version: Laboratory Manual…
Benson's Microbiological Applications has been the gold standard of microbiology laboratory manuals for over 30 years. The 77 self-contained, clearly-illustrated exercises, and four-color format with a wealth of added photographs makes this the ideal lab manual. Appropriate for either a majors or non-majors lab course, this manual assumes no prior organic chemistry course has been taken.
- Edisi
- Edisi 13
- ISBN/ISSN
- 9780073402413
- Deskripsi Fisik
- 481 halaman, ilus.
- Judul Seri
- -
- No. Panggil
- 616.01 BRO b
E-book Food Economics :Agriculture, Nutrition, and Health
Each reader of this book brings its pages to life, using your own history and insights to interpret and apply what we have written. Before writing this book, Amelia and William were students then researchers and teachers in a variety of places. We worked in agricultural schools, liberal arts colleges and health-science campuses in the U.S., E…
- Edisi
- -
- ISBN/ISSN
- 9783031538407
- Deskripsi Fisik
- 498 hlm
- Judul Seri
- -
- No. Panggil
- 338.1 MAS f
E-book Ableism in Academia : Theorising experiences of disabilities and chron…
In the contemporary context of social rights and activist movements such as those associated with combatting sexual harassment, gun and knife crime or climate change, we can observe a typical pattern of public responses. These movements offer voices to those who are marginalised, and indeed provide the confidence needed for many people to stand up for specific issues. This, …
- Edisi
- -
- ISBN/ISSN
- 9781787354975
- Deskripsi Fisik
- 263 hlm
- Judul Seri
- -
- No. Panggil
- 305.908 BRO a
E-book Nature Guiding
One of the difficulties in the establishment of nature-study has been that there is no field for the work. This is no longer true. There is an awakening throughout the country. 1. Summer Camps need Nature Counsellors. It is admitted that nature lore is the most important and the most difficult position to fill in the summer camp. There are over 5000 camps. 2. Scouting and Camp Fire Organiz…
- Edisi
- -
- ISBN/ISSN
- 9781501740862
- Deskripsi Fisik
- -
- Judul Seri
- -
- No. Panggil
- 570 VIN n
E-book A Matter of Trust : Building Integrity into Data, Statistics and Recor…
The Sustainable Development Goals (SDGs) initiative has the potential to set the direction for a future world that works for everyone. The SDGs were approved by 193 United Nations member countries in September 2016 to help guide global and national development policies in the period to 2030. The 17 goals build on the successes of the Millennium Development Goals, while also includin…
- Edisi
- -
- ISBN/ISSN
- 9781912250356
- Deskripsi Fisik
- 269 hlm
- Judul Seri
- -
- No. Panggil
- 300.285 AMB a
E-book Splendors of Quanzhou, Past and Present
Zaytun’s True Wealth Marco Polo was impressed by Zaytun’s gems, pearls, porcelain, and silk, but he overlooked the true wealth of this mythic port—the place and the people! Zaytun was blessed with an unparalleled natural wealth and beauty that the enlightened inhabitants maintained as meticulously as their miniature landscapes, which have been…
- Edisi
- -
- ISBN/ISSN
- 9789811980367
- Deskripsi Fisik
- 139 hlm
- Judul Seri
- -
- No. Panggil
- 950.4 BRO s
E-book Undocumented Saints : The Politics of Migrating Devotions
For some people life begins only after death; for others, life is a shifting journey toward a better place. As a kid, I dreamed of becoming a priest, and as a young adult, I lived for a few years in a consecrated community in Florence, Italy.1 Those years joyfully, and painfully, transformed my relation-ship with the Catholic Church. They helped me distinguish the in…
- Edisi
- -
- ISBN/ISSN
- 9780197630228
- Deskripsi Fisik
- 369 hlm
- Judul Seri
- -
- No. Panggil
- 282 CAL u

E-book Eyewitness Travel: Top 10 Phuket
With hot spots such as lively Phuket Town and the sprawling Patong beach resort, this guide allows you to discover the best of everything Thailand's biggest island has to offer. Five easy-to-follow itineraries explore the city's most interesting areas—from beautiful karst islands to idyllic bays—while reviews of the best hotels, restaurants, and nightlife in Phuket help you plan your perfec…
- Edisi
- -
- ISBN/ISSN
- -
- Deskripsi Fisik
- 130 halaman, ilus.
- Judul Seri
- -
- No. Panggil
- 910.2 BRE e
Materials Science and Engineering : An Introduction
Materials are probably more deep-seated in our culture than most of us realize. Transportation, housing, clothing, communication, recreation, and food production virtually every segment of our everyday lives is influenced to one degree or another by materials. Historically, the development and advancement of socities have been intimately tied to the members's ability to produce and manipulate m…
- Edisi
- -
- ISBN/ISSN
- 0471320137
- Deskripsi Fisik
- xxi + 871 hlm; 21 x 26 cm
- Judul Seri
- -
- No. Panggil
- 620.11 JUN m

E-book Beyond Neoliberalism and Neo-illiberalism: Economic Policies and Perfo…
In many countries, the political backlash against neoliberalism has mainly been a retreat from democracy, with a decline in independence of the judiciary and the monetary authorities, increased control of the media, and manipulation of elections for purposes of authoritarian control. The economic dynamics and the impact of neoliberalism, i.e. deregulation and liberalized markets, is just one ca…
- Edisi
- -
- ISBN/ISSN
- 9783839474877
- Deskripsi Fisik
- 232 halaman
- Judul Seri
- -
- No. Panggil
- 320.01 GAB b

E-book William Sharp and “Fiona Macleod” : A Life
William Sharp was born on September 12, 1855, at 4 Garthland Place in Paisley, Scotland. He was the oldest in a family of five daughters and three sons. His father, David Galbreath Sharp, was a partner in a mercantile house, and his mother, Katherine Brooks, was the daughter of the Swedish Vice Consul in Glasgow. Sharp spent the summers of his chi…
- Edisi
- -
- ISBN/ISSN
- 9781800643284
- Deskripsi Fisik
- 477 hlm
- Judul Seri
- -
- No. Panggil
- 821 HAL w

E-book Theoretical Knowledge in the Mohist Canon
Anyone undertaking a long-term historical study of any particular field of human activity is confronted with the difficulty that the contents and boundaries of that field are inevitably fluid and change over time. The historical study of science is no exception to this. Is it possible to conceptualize science broadly enough to include what has traditionally been considered sci…
- Edisi
- -
- ISBN/ISSN
- 9783031087974
- Deskripsi Fisik
- 215 hlm
- Judul Seri
- -
- No. Panggil
- 931 SCH t

E-book China's Last Empire: The Great Qing
In a brisk revisionist history, William Rowe challenges the standard narrative of Qing China as a decadent, inward-looking state that failed to keep pace with the modern West. The Great Qing was the second major Chinese empire ruled by foreigners. Three strong Manchu emperors worked diligently to secure an alliance with the conquered Ming gentry, though many of their social edicts—especial…
- Edisi
- -
- ISBN/ISSN
- 9780674066243
- Deskripsi Fisik
- 369 halaman
- Judul Seri
- -
- No. Panggil
- 931 ROW c
E-book Garranes : An Early Medieval Royal Site in South-West Ireland
The significance of Garranes lies partly in the date of Lisnacaheragh, believed to have been built in the fifth century AD. That is early in the history of the Irish ringfort, the origins of which remain unclear. The evidence of specialist craftworking in metal, glass and enamel from Lisnacaheragh testifies to the importance of the site. The dis…
- Edisi
- -
- ISBN/ISSN
- 9781789699197
- Deskripsi Fisik
- 402 hlm
- Judul Seri
- -
- No. Panggil
- 930.1415 OBR g
E-book Observing the Volcano World : Volcano Crisis Communication
Effective volcanic crisis communication is afundamental component of the concepts of miti-gation, disaster management, and disaster riskreduction. As part of this communication pro-cess, a number of tools have emerged that areregularly employed in volcanic crises that assistin the structure and formulation of communica-tive processes. This chapter focuses on four vitallessons learnt from key cr…
- Edisi
- -
- ISBN/ISSN
- 9783319440972
- Deskripsi Fisik
- 754 hlm
- Judul Seri
- -
- No. Panggil
- 551.21 FEA o

E-book Not Written in Stone: Jews, Constitutions, and Constitutionalism in Ca…
Using long-ignored constitutions of various Jewish organizations, this unique book uncovers the political history of Canadian Jewry since its beginning during the 1700s. Building on the premise that Jews, since time immemorial, have written down their values and ideologies, this study effectively demonstrates how these writings record the principles and values that motivated a community.
- Edisi
- -
- ISBN/ISSN
- 9780776605456
- Deskripsi Fisik
- 295 halaman
- Judul Seri
- -
- No. Panggil
- 302.17 ELA n
E-book Small-scale fishing techniques using light : A Manual for Fishermen
This manual presents some of the small-craft night baiting and fishing techniques commonly used in the Pacific Islands region, and provides Pacific Island fishermen with information that may help develop their small-craft commercial fishing operations. Some of the techniques are improvements in canoe fishing methods and use basic gear, while other techniques include modern fishing equipment use…
- Edisi
- -
- ISBN/ISSN
- 9789820004498
- Deskripsi Fisik
- 61 hlm
- Judul Seri
- -
- No. Panggil
- 639.2 SOK s
E-book Vanishing Sands : Losing Beaches to Mining
- Edisi
- -
- ISBN/ISSN
- 9781478023432
- Deskripsi Fisik
- 265 hlm
- Judul Seri
- -
- No. Panggil
- -
- Edisi
- -
- ISBN/ISSN
- 9781478023432
- Deskripsi Fisik
- 265 hlm
- Judul Seri
- -
- No. Panggil
- -
E-book Smell and the Past : Noses, Archives, Narratives
What if we were actually able to smell out the mixture of things that composed the olfactory past? What if historians were to bury their noses in the past instead of merely resorting to ocular inspection?This short book provides some answers to these questions. It is an exploration of what it means to study smell in the past, smell and the past and the smell of the pas…
- Edisi
- -
- ISBN/ISSN
- 9781350367548
- Deskripsi Fisik
- 161 hlm
- Judul Seri
- -
- No. Panggil
- 901 TUL s
E-book Down to Earth Archaeology
Down to Earth Archaeology collects sixteen archaeological papers by Professor William Y. Adams chosen by the author, who added introductory commentary to each. These articles were written at various times during his lengthy and productive academic career for different purposes and for different audiences. Most of those selected had been previously published only in a limited way, either as conf…
- Edisi
- -
- ISBN/ISSN
- 9781803272306
- Deskripsi Fisik
- 244 halaman, ilus.
- Judul Seri
- -
- No. Panggil
- 930.1 ADA d

E-book 1000 Inventions and Discoveries
From making fire to building the gadgets of the 21st century, uncover the stories behind the remarkable ideas and devices that have shaped our world in 1,000 Inventions and Discoveries. This revised and updated edition brings this comprehensive review of humanity's greatest ideas up to date. Innovations in science, space, technology, transportation, medicine, mathematics, and language are cove…
- Edisi
- -
- ISBN/ISSN
- 9781465420381
- Deskripsi Fisik
- 258 halaman, ilus.
- Judul Seri
- -
- No. Panggil
- 608 BRI o
E-book The Art of Living : Vipassana Meditation
The qualities of Vipassana are exemplified by Mr. Goenka, himself. He is a pragmatic person, in touch with the ordinary realities of life and able to deal with them incisively, but in every situation he maintains an extraordinary calmness of mind. Along with that calmness is a deep compassion for others, an ability to empathize with virtually any human being. There is however, nothing solemn ab…
- Edisi
- -
- ISBN/ISSN
- 978192870673
- Deskripsi Fisik
- 164 hlm
- Judul Seri
- -
- No. Panggil
- 204 HAR t
E-book Capability Brown, Royal Gardener : The Business of Place-Making in Nor…
Yet Brown’s family lived in Kirkhale, in Northumberland, a fairly typical small rural community, over 300 miles to the north, far from the glittering metropolitan world. His father, who died in 1720 when Brown was only four, was a farmer and land agent to the local lord, Sir William Loraine, yet the young Brown was educated at the local school in Cambo – possibly through the good offices of…
- Edisi
- -
- ISBN/ISSN
- 9781912482252
- Deskripsi Fisik
- 241 hlm
- Judul Seri
- -
- No. Panggil
- 712.5 BOT c
E-book The Gifts of Imperfection: Embrace Who You Are
Dr. Brené Brown, a research professor and thought leader on vulnerability, courage, worthiness, and shame, shares ten guideposts on the power of Wholehearted living—a way of engaging with the world from a place of worthiness.
- Edisi
- -
- ISBN/ISSN
- 9781592859894
- Deskripsi Fisik
- 98 halaman
- Judul Seri
- -
- No. Panggil
- 155.25 BRO t
E-book Dark Psychology Secrets
Has someone ever taken advantage of you for their benefit? Do you want to learn to defend yourself against Mental Manipulation or do you want to learn easy how to use Dark Psychology to get what you want from people without them even knowing it? You should know that most of our choices are generated and managed through the application of specific methods of Covert Manipulation. Knowing these …
- Edisi
- -
- ISBN/ISSN
- 9798555483072
- Deskripsi Fisik
- 124 halaman
- Judul Seri
- -
- No. Panggil
- 150.1 COO d
E-book The Encyclopedia of Embroidery Techniques
- Edisi
- -
- ISBN/ISSN
- 0855329858
- Deskripsi Fisik
- 178 halaman, ilus.
- Judul Seri
- -
- No. Panggil
- 746.2 BRO t
- Edisi
- -
- ISBN/ISSN
- 0855329858
- Deskripsi Fisik
- 178 halaman, ilus.
- Judul Seri
- -
- No. Panggil
- 746.2 BRO t
Boletes of Eastern North America
- Edisi
- -
- ISBN/ISSN
- 9780815653943
- Deskripsi Fisik
- 495 halaman, ilus.
- Judul Seri
- -
- No. Panggil
- 579.6 BES b
- Edisi
- -
- ISBN/ISSN
- 9780815653943
- Deskripsi Fisik
- 495 halaman, ilus.
- Judul Seri
- -
- No. Panggil
- 579.6 BES b
E-book Llewellyn's 2024 Herbal Almanac: A Practical Guide to Growing, Cooking…
- Edisi
- -
- ISBN/ISSN
- 9780738768953
- Deskripsi Fisik
- 194 halaman, ilus.
- Judul Seri
- -
- No. Panggil
- 635.7 HEI l
- Edisi
- -
- ISBN/ISSN
- 9780738768953
- Deskripsi Fisik
- 194 halaman, ilus.
- Judul Seri
- -
- No. Panggil
- 635.7 HEI l
 Karya Umum
Karya Umum  Filsafat
Filsafat  Agama
Agama  Ilmu-ilmu Sosial
Ilmu-ilmu Sosial  Bahasa
Bahasa  Ilmu-ilmu Murni
Ilmu-ilmu Murni  Ilmu-ilmu Terapan
Ilmu-ilmu Terapan  Kesenian, Hiburan, dan Olahraga
Kesenian, Hiburan, dan Olahraga  Kesusastraan
Kesusastraan  Geografi dan Sejarah
Geografi dan Sejarah